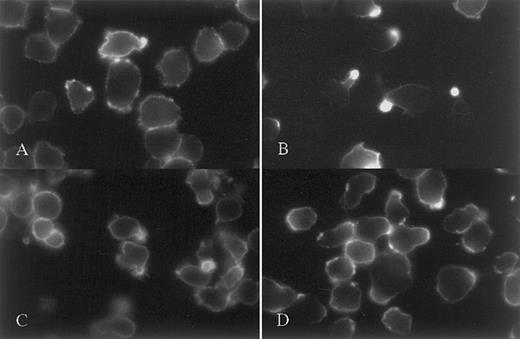
Fig. 2. Staining of CAG myeloma cells against CD43, CD38 and syndecan-1. / Evidence of uropod targeting as a dynamic process. CAG cells were stained against CD43 either at 20°C after fixation (A) or at 37° before fixation (B). Uropod restriction of CD43 was seen only when live cells were stained. (C) shows uniform expression of CD38 over the cell surface in cells stained live at 37°C. (D) shows lack of syndecan-1 polarization in cells stained live at 4°C.

Abstract
Syndecan-1 (CD138) is a heparan sulfate-bearing proteoglycan present on the surface of myeloma cells where it mediates myeloma cell-cell and cell-extracellular matrix adhesion. In this study, we examined myeloma cell lines for cell membrane localization of syndecan-1. On some cells we note a striking localization of syndecan-1 to a single small membrane protrusion, with the remainder of the cell surface being mostly negative for syndecan-1. Examination of cell morphology reveals that a proportion of cells from myeloma cell lines, as well as primary myeloma cells, are polarized, with a uropod on one end and lamellipodia on the other end. On these polarized cells, syndecan-1 is specifically targeted to the uropod, but in contrast, on nonpolarized cells syndecan-1 is evenly distributed over the entire cell surface. In addition to syndecan-1, several other cell surface molecules localize specifically to the uropod, including CD44 and CD54. Functional assays reveal that myeloma cell lines with a high proportion of polarized cells have a much higher migratory potential than cell lines with few polarized cells. Moreover, the uropod is the cell pole preferentially involved in aggregation of myeloma cells and in adhesion of myeloma cells to osteoblast-like cells. When polarized myeloma cells are incubated with heparin-binding proteins, like hepatocyte growth factor or osteoprotegerin, they concentrate in the uropod. These data indicate that syndecan-1 is targeted to the uropod of polarized myeloma cells and that this targeting plays a role in promoting cell-cell adhesion and may also regulate the biological activity of heparin-binding cytokines.
Introduction
Myeloma cells are malignant plasma cells that are typically localized in the bone marrow (BM) of patients with multiple myeloma (MM). Syndecan-1, a transmembrane heparan sulfate-bearing proteoglycan, is expressed by plasma cells in normal human bone marrow and, in addition, by myeloma cells in MM patients. Although the function of syndecan-1 in myeloma cells is not fully understood, we have previously demonstrated that it mediates homotypic cell aggregation, promotes cell binding to matrix proteins like type I collagen, and prevents invasion of myeloma cells into type I collagen gels.1-3 Syndecan-1 has been shown to accumulate at interfaces between aggregating cells,3 but localization of syndecan-1 to subcellular membrane domains has not been described in myeloma cells.
The critical oncogenic event leading to MM is unknown, but possibly involves an illegitimate gene recombination during immunoglobulin isotype switching, a process taking place in a lymph node.4 Migration of the subsequent myeloma cell precursor from the lymph node to BM involves crossing of endothelial-cell barriers. Similarly, further spread of MM cells throughout the skeleton and of clonally related cells into blood requires directed motility through vascular and sinusoidal channels.5 6 Myeloma cell clones thus have to include cells capable of active migration.
Active locomotion, as opposed to passive movement in circulation, allows normal immune cells to reach target sites. In the transition from passive to active movement, the cells rearrange their cytoskeletons and change from roughly spherical in shape to elongated or polarized, probably under the influence of chemokines.7,8 The elongated cells develop a leading edge termed “lamellipodia” and a somewhat narrower trailing edge, called “the uropod.”9 Several cell surface molecules redistribute to the uropod of migrating immune cells, including surface immunoglobulin,10 intercellular adhesion molecules (ICAM)-1-2 and 3,11,12 CD43, and CD44.13 The specific function of polarized immune cells is not restricted to locomotion, as the uropod has also been shown to promote cell adhesion and cell-cell communication.12 14
In this paper, we show that some myeloma cells are polarized with distinct uropods and that several cell surface molecules are preferentially localized to the uropod of the cells, including CD44 and CD54 (ICAM-1), whereas other molecules are evenly distributed throughout the cell membrane. As expected, this particular phenotype was linked to the ability of cells to actively move through porous membranes. In addition, we show for the first time that the heparan sulfate proteoglycan syndecan-1 is localized specifically to the uropod of polarized myeloma cells where it promotes homotypic cell-cell adhesion and concentrates heparin-binding proteins.
Patients, materials, and methods
Antibodies and reagents
The following mouse monoclonal antibodies (mabs) were used: anti-CD43 (IgG1) and fluorescin isothiocyanate-labeled (FITC) anti-CD138 (IgG1, clone B-B4) from Serotec (Oxford, UK); anti-CD54 (IgG1) from Upstate Biotechnology (Waltham, MA); antiheparan sulfate 10E4 (mouse IgM) from Seikagaku Amerika (Falmouth, MA); anti-CD38, FITC-anti-CD45, and FITC-anti-CD44 from Becton Dickinson (San Jose, CA); FITC-goat antihuman IgG+A+M (H+L) from Zymed (South San Francisco, CA); antiosteoprotegerin (OPG) (IgG2A) from R&D Systems (Minneapolis, MN); and antihuman HGF (3F4) established by us as described.15 Rat-adsorbed and affinity-purified horse FITC-antimouse IgG (H+L) from Vector Laboratories (Burlingame, CA) was used as a secondary antibody. Human hepatocyte growth factor (HGF) was purified from a myeloma cell supernatant as previously described,15 full-length human OPG was from R&D Systems, OPG lacking the C-terminal heparin-binding domain from PeproTech (Rocky Hill, NJ), human fibronectin from Becton Dickinson, and heparin from Leo (Ballerup, Denmark).
Cell lines
ARH-77, U-266, and RPMI-8226 cells were obtained from American Type Culture Collection (Manassas, VA). ARK and CAG cell lines were established at the Arkansas Cancer Research Center from Histopaque-1077 (Sigma)-separated BM aspirates taken form myeloma patients. In the case of CAG cells, myeloma BM cells were injected into a SCID mouse. The cell line was established from cells recovered from the mouse and expresses the same Ig isotype and complementarity-determining region III as the original patient cells. ARH-77 are Epstein-Barr virus (EBV)-positive lymphoblastoid cells established from a plasma cell leukemia patient, whereas all the other cell lines are EBV-negative human myeloma cells. ARH-77 cells, which do not express syndecan-1, were transfected with murine syndecan-1 complementary DNA (cDNA) as described (designated ARH-77A5P3).1 The human osteosarcoma cell line HOS was a kind gift from Dr Etsuko Abe. All cell lines were grown in RPMI 1640 with 10% fetal calf serum (complete medium [CM]).
Patient and control samples
Primary samples were obtained after informed consent from patients at the Myeloma and Transplantation Research Center, University of Arkansas for Medical Sciences. Mononuclear cells from peripheral blood and from a BM aspirate of a patient with plasma cell leukemia were isolated by density gradient centrifugation. The cells were resuspended in CM and incubated at 37°C for 2 hours until the cells were used for staining or migration assays. Bone biopsy specimens were obtained from 3 myeloma patients. They were minced to release single cells, which subsequently were cultured in CM until staining against surface markers. Bone marrow aspirates were obtained from 7 voluntary donors. Mononuclear cells were isolated from these samples, seeded on chamber slides precoated with fibronectin, and grown overnight before staining against syndecan-1.
Immunostaining of cell surface molecules
Staining was performed with live cells or after fixation of the cells. Live cells were washed, seeded in 24-well plates (Costar, Corning, NY) in 0.5 mL CM, and stained at 37°C for 45 minutes with either FITC-conjugated mabs (anti-CD44, anti-CD138, and goat antihuman IgG+A+M [H+L]) or unconjugated antibodies (all other antibodies). Then they were fixed in 3.7% formaldehyde in phosphate-buffered saline (PBS) for 5 minutes, gently centrifuged, resuspended in PBS, and spun onto polylysine-coated slides with a Shandon cytospin-3 centrifuge (700 rpm, 5 minutes). Slides were rinsed several times in PBS and, if the primary antibody was unconjugated, secondary staining was performed with 2 μL FITC-conjugated affinity-purified horse antimouse IgG (H+L) in 50 μL of PBS with 1% fetal calf serum. When cells were fixed before primary staining, the fixative was added directly to live cells in CM, giving a final concentration of 3.7% formaldehyde. Cytospin slides were immediately prepared and staining steps performed with several rinses in PBS after each step. Because the cells were fixed before cytospin preparation, the cytospin centrifugation did not in any observable way alter cell polarity or uropod integrity, compared with cells growing in suspension.
In experiments showing binding of HGF or OPG to myeloma cells, CAG and ARP-1 cells were incubated in a 24-well plate with 4 μg/mL of HGF (both cell lines), with a combination of HGF and 40 μg/mL of heparin (CAG cells only) or with 10 μg/mL of OPG (CAG cells only) at 37°C for 45 minutes, before fixation and preparation of cytospin slides. We used 2 variants of recombinant human OPG, either full-length OPG or a deletion mutant lacking the heparin-binding domain. After several washes in PBS, slides were incubated with 2 μg of anti-HGF (3F4) or anti-OPG, washed again, and incubated with FITC-anti-mouse IgG. Control slides were prepared with cells not incubated with HGF or OPG.
In some experiments, staining was performed with cells growing on 4-chamber slides (Nalge Nunc International, Naperville, IL) precoated with fibronectin (20 μg/mL) (Becton Dickinson) or polylysine (100 μg/mL) (Sigma). Staining was performed either in 500 μL medium/chamber (live cells at 37°C) or in 300 μL PBS with 1% fetal calf serum (staining after fixation).
One drop of Vectashield mounting medium (Vector Laboratories) was added before mounting coverslips.
The slides were studied by fluorescence and phase contrast microscopy with an Olympus BX60 microscope applied with a BX-FLA reflected light fluorescence attachment (Olympus, Tokyo, Japan) or with an Axiovert 135 microscope from Zeiss (Oberkochen, Germany). Analog pictures were taken with a 35-mm Olympus camera (Olympus microscope) and digital pictures with a Chilled CCD camera from Hamamatsu (Bridgewater, NJ) (Zeiss microscope).
CD45 expression was analyzed with a FACScan flow cytometer (Becton Dickinson) after staining of 106 cells from each cell line with FITC-labeled anti-CD45 and washing 3 times in PBS with 0.1% bovine serum albumin. Propidium iodide (PI) (10 μg/mL) was added before analysis. PI-positive cells were considered dead and excluded from analysis by gating.
Assessment of cell polarization
In assessment of percentage of cells with a polarized phenotype, two approaches were used. First, cells were studied by phase contrast microscopy and were considered polarized if they were elongated with a ratio higher than 2 between their length and their broadest width (perpendicular to the length), or if they had a cell protrusion with the characteristic appearance of a uropod. Second, polarization of ICAM-1 and syndecan-1 was assessed after appropriate staining. In each case, more than 200 cells were counted in randomly chosen visual fields.
Assessment of homotypic and heterotypic cell-cell attachment
Homotypic cell aggregation was assessed by phase contrast microscopy of live cells growing in 25 cm2 culture flasks or by differential interference contrast (DIC) microscopy of cells growing on 60-mm petri dishes.
In coculture experiments in which MM cells were growing on top of osteosarcoma cells, HOS cells were seeded in 4-chamber wells and cultured until confluence. After removal of the medium, MM cell line cells were added and the coculture maintained until attachment of the MM cells. Attachment was evaluated by phase contrast microscopy of live cells and by confocal laser microscopy after fixation and staining of the cells against syndecan-1. Confocal microscopy was performed with a LSM 410 inverted laser scan microscope (Zeiss). A z-section was made by computing information from 60 stacked pictures in the x-y plane. The distance between each picture in the x-y plane was 0.5 μm.
Migration assay
Myeloma cells were centrifuged, resuspended in CM, and seeded in the upper compartment of a Transwell (Costar) (5 × 105cells per well). All samples were performed in triplicate. The volume of medium was 200 μL in the upper compartments and 700 μL in the lower compartments. After 24 hours, the number of cells that had migrated through the membrane to the lower chamber was determined by a Coulter Counter Z1 (Beckman Coulter, Fullerton, CA).
Results
Syndecan-1 is targeted specifically to uropods of polarized myeloma cells
Previous studies demonstrate that syndecan-1 is localized specifically to the basolateral cell surface of polarized epithelial cells.16 After noticing that some myeloma cells in culture exhibit a polarized phenotype, we stained them with antibody to syndecan-1 to determine whether the proteoglycan was targeted to a specific membrane domain. In all myeloma cell lines examined, syndecan-1 was concentrated in the narrower cell pole, or uropod, of the polarized cells that were present (Figure1G-K), whereas it was evenly distributed throughout the cell membrane in nonpolarized cells (Figure 1L). ARH-77 cells, which express little if any syndecan-1,17 when transfected with the cDNA for syndecan-1, also concentrated the proteoglycan in the uropod (Table 1, ARH-77A5P3). Interestingly, cells incubated and stained against syndecan-1 at 4°C for 45 minutes before fixation showed no concentration of syndecan-1 in the uropods, even though uropods were at least partly preserved (Figure 2D). This indicates that syndecan targeting to uropod membranes is an energy-dependent process.
Targeting of cell surface molecules to the uropods of myeloma cell lines.
CAG cells (A-C and G-H), ARP-1 cells (F and I), U-266 cells (D-E and J-K), and ARK cells (L) were stained against CD44 (A), ICAM-1 (C-F), or syndecan-1 (G-L). ICAM-1 and syndecan-1 staining was performed after fixation of the cells, whereas CD44 staining was performed on live cells at 37°C. A-B, D-E, G-H, and J-K are corresponding visual fields. The figure shows polarization of these molecules to uropods in cells expressing uropods. Nonpolarized cells have uniform expression of these molecules over the entire cell surface, as shown for syndecan-1 in ARK cells (L).
Targeting of cell surface molecules to the uropods of myeloma cell lines.
CAG cells (A-C and G-H), ARP-1 cells (F and I), U-266 cells (D-E and J-K), and ARK cells (L) were stained against CD44 (A), ICAM-1 (C-F), or syndecan-1 (G-L). ICAM-1 and syndecan-1 staining was performed after fixation of the cells, whereas CD44 staining was performed on live cells at 37°C. A-B, D-E, G-H, and J-K are corresponding visual fields. The figure shows polarization of these molecules to uropods in cells expressing uropods. Nonpolarized cells have uniform expression of these molecules over the entire cell surface, as shown for syndecan-1 in ARK cells (L).
Staining of CAG myeloma cells against CD43, CD38 and syndecan-1.
Evidence of uropod targeting as a dynamic process. CAG cells were stained against CD43 either at 20°C after fixation (A) or at 37° before fixation (B). Uropod restriction of CD43 was seen only when live cells were stained. (C) shows uniform expression of CD38 over the cell surface in cells stained live at 37°C. (D) shows lack of syndecan-1 polarization in cells stained live at 4°C.
Staining of CAG myeloma cells against CD43, CD38 and syndecan-1.
Evidence of uropod targeting as a dynamic process. CAG cells were stained against CD43 either at 20°C after fixation (A) or at 37° before fixation (B). Uropod restriction of CD43 was seen only when live cells were stained. (C) shows uniform expression of CD38 over the cell surface in cells stained live at 37°C. (D) shows lack of syndecan-1 polarization in cells stained live at 4°C.
In addition to syndecan-1, ICAM-1 was tightly concentrated in the uropods of myeloma cells (Figure 1C-F). Both syndecan-1 and ICAM-1 were concentrated in the uropod, irrespective of whether incubation with primary antibody was performed at 37°C before fixation or at room temperature after fixation. However, for syndecan-1, the localization was even more focal when staining was performed on live cells at 37°C. Like syndecan-1, ICAM-1 was evenly distributed around the cell circumference in nonpolarized myeloma cells (Figure 1D). Another molecule that showed uropod polarization was the hyaluronic acid receptor, CD44 (examined in CAG cells only, as seen in Figure 1A).
CD43, a sialoprotein, which among other functions binds to ICAM-1, is reported to redistribute to uropods when T cells and neutrophils become polarized.18 Four of the 6 cell lines and the primary plasma cell leukemia cells strongly expressed CD43 (U266 cells were negative and RPMI 8226 had weak expression). When expressed, CD43 was evenly distributed on the cell surface, provided staining was performed after fixation of the cells (Figure 2A). However, when live CAG cells were incubated with anti-CD43 at 37°C for 45 minutes before fixation, 51% of the cells had redistributed CD43 to the uropod (Figure 2B) (secondary staining with FITC-labeled antimouse-Ig was performed after fixation, ruling out cross-linking of aggregates of CD43). CD38, another marker molecule for plasma cells, was by and large evenly distributed in the membrane, both when staining was performed at 37°C and when it was performed after fixation (Figure 2C). Surface immunoglobulin was expressed only in ARH-77 cells, but did not target to the uropod (not shown).
In addition to cell lines, targeting of syndecan-1 and ICAM-1 to uropods was also seen in the malignant cells from a patient with plasma cell leukemia. Almost 50% of the malignant cells had prominent uropods, and among these polarized cells nearly all had specific targeting to the uropods of both syndecan-1 (Figure 3B,D) and ICAM-1 (not shown). Syndecan-1 targeting was also evident in primary myeloma cells isolated from the bone marrow of an MM patient (Figure 3F,H). To see whether polarization of syndecan is found in normal plasma cells, we obtained bone marrow cells from 7 healthy donors, cultured the mononuclear cells overnight and stained against syndecan-1 at 37°C. In the population of syndecan-1-positive cells, polarization with a uropod-like extension was rarely found, and targeting of syndecan-1 to such extensions was even more uncommon. In all samples, less than 0.5% of the cells belonged to this category (Figure 3I,J).
Syndecan-1 is targeted to the uropod of primary malignant and normal plasma cells.
Primary malignant plasma cells from the peripheral blood of a patient with plasma cell leukemia (A-D) and from the BM of a patient with MM (E-H) were cultured for 2 hours and stained at 37°C against syndecan-1. (A), (C), (E), (G), and (I) are phase contrast micrographs and show the same visual fields as (B), (D), (F), (H), and (J), respectively. The immunofluorescence micrographs (B), (D), (F), and (H) show polarization of syndecan-1 in cells expressing uropods, whereas cells without uropods have syndecan-1 evenly distributed. Similar syndecan-1 polarization was an uncommon observation in normal bone marrow plasma cells (I-J). Arrows point to uropods and arrowheads to cell bodies. Pictures (A-B) were photographed with an analog camera, (C-J) with a digital camera.
Syndecan-1 is targeted to the uropod of primary malignant and normal plasma cells.
Primary malignant plasma cells from the peripheral blood of a patient with plasma cell leukemia (A-D) and from the BM of a patient with MM (E-H) were cultured for 2 hours and stained at 37°C against syndecan-1. (A), (C), (E), (G), and (I) are phase contrast micrographs and show the same visual fields as (B), (D), (F), (H), and (J), respectively. The immunofluorescence micrographs (B), (D), (F), and (H) show polarization of syndecan-1 in cells expressing uropods, whereas cells without uropods have syndecan-1 evenly distributed. Similar syndecan-1 polarization was an uncommon observation in normal bone marrow plasma cells (I-J). Arrows point to uropods and arrowheads to cell bodies. Pictures (A-B) were photographed with an analog camera, (C-J) with a digital camera.
Polarized cells represent a distinct subpopulation of myeloma cells in vitro and in vivo
The observation that syndecan-1 has a particular localization in polarized myeloma cells prompted us to investigate the prevalence, characteristics, and functional properties of cells having a polarized morphology. Six cell lines were examined. ARP-1 (Table 1 and Figure1I), CAG (Table 1, Figure 1H, and Figure4) and ARH-77A5P3 cells (Table 1) had 50% to 90% polarized cells. U-266 (Table 1 and Figure1E) and ARK cells (Table 1 and Figure 1L) had almost exclusively round or ovoid cells and only a few percentage polarized cells. In RPMI 8226 approximately 25% of the cells were polarized (Table 1).
Polarization of CAG myeloma cells.
DIC image of live CAG cells. White arrows point to uropods and black arrows point to lamellipodia.
Polarization of CAG myeloma cells.
DIC image of live CAG cells. White arrows point to uropods and black arrows point to lamellipodia.
Polarized myeloma cells had a narrow end and a broad end, closely resembling the uropod and lamellipodia, respectively, of motile lymphocytes (Figure 4). Polarization was not dependent on surface attachment of the cells because even cells growing in suspension had well-formed uropods (not shown). In all cultures with polarized myeloma cells, there was a continuum of morphology from spherical plasma-cell–like cells to cells with prominent uropods and lamellipodia (Figures 1 and 3A). Polarization of the individual cell lines did not correlate with differentiation level as examined by CD45 expression. Both predominantly polarized cell lines and unpolarized lines were either mature (CD45−) or less differentiated (CD45+) (Table 1).
The same polarized plasma cell phenotype was also found among freshly isolated malignant cells from peripheral blood of a patient with secondary plasma cell leukemia. Of the 60% cells identified as malignant by expression of syndecan-1 (syndecan-1 is normally found on less than 0.1% of leukocytes in the peripheral blood19), 46% had well-developed uropods (Figure 3A). In a sample taken from the BM of the same patient 45% of the cells expressing syndecan-1 had uropods by morphologic criteria.
Bone core samples from 3 patients with MM were minced to release single cells. After staining against syndecan-1, morphology of the malignant cells was evaluated. In all 3 samples, a minor fraction of MM cells showed polarized morphology. In 2 of them, less than 0.5% of the cells had this morphology, whereas in the third patient, 5.6% of the cells were polarized with uropods (Figure 3E,G).
The pattern of syndecan-1 and ICAM-1 expression is altered by growth of cells on fibronectin
As several investigators have reported, myeloma cells attach to surfaces coated with fibronectin.20 21 When CAG cells or ARP-1 cells were grown on fibronectin, the cells' morphology was altered (Figure 5). One or more filopodia typically protruded from the uropod and the lamellipodia were flattened out and appeared broader than when grown on a polylysine or collagen type I-coated surface (not shown). Eventually some cells attained a spindle-shaped appearance. However, the polarity with a broader and a narrower end was preserved. Syndecan-1 and ICAM-1 retained their focal expression in CAG cells grown on fibronectin. Surprisingly, these molecules were no longer localized to the distal rear end of the uropod, but to the neck of the uropod, close to the nuclear region (Figure 5B-D). It was unusual to see the stained region in direct contact with the fibronectin-coated surface, arguing against a function of syndecan-1 and ICAM-1 in the binding to this substrate. More often, the region positive for syndecan-1 and ICAM-1 staining would bud out from the cell soma sideward or upward, as seen in Figure 5E-F.
Growth of cells on fibronectin alters polarization of cell surface molecules.
CAG cells were grown on fibronectin-coated chamber slides, stained against ICAM-1 or syndecan-1, fixed, and photographed through an inverted phase contrast or a fluorescence microscope. The phase contrast image (A) shows cell morphology with filopodia extending from the uropods. Cells in picture (B) (same field as A) are stained against ICAM-1 and cells in pictures (C-D) against syndecan-1. Both these molecules are polarized to an area located on the cell body at the neck of the uropod. (E-F) show syndecan-1 expression in uropods pointing toward the outer environment. In (E), the microscope is focused on the interface between the glass surface and the cells and the syndecan hotspots in the uropods appear blurred. (F) shows the same cells as in (E) with the focal plane elevated some 10 μm above the slide surface. Syndecan is now in focus, showing that the uropods are oriented upward.
Growth of cells on fibronectin alters polarization of cell surface molecules.
CAG cells were grown on fibronectin-coated chamber slides, stained against ICAM-1 or syndecan-1, fixed, and photographed through an inverted phase contrast or a fluorescence microscope. The phase contrast image (A) shows cell morphology with filopodia extending from the uropods. Cells in picture (B) (same field as A) are stained against ICAM-1 and cells in pictures (C-D) against syndecan-1. Both these molecules are polarized to an area located on the cell body at the neck of the uropod. (E-F) show syndecan-1 expression in uropods pointing toward the outer environment. In (E), the microscope is focused on the interface between the glass surface and the cells and the syndecan hotspots in the uropods appear blurred. (F) shows the same cells as in (E) with the focal plane elevated some 10 μm above the slide surface. Syndecan is now in focus, showing that the uropods are oriented upward.
In a time lapse study, CAG cells were grown on a fibronectin-coated surface, stained with FITC-antisyndecan-1, and followed in a fluorescence microscope. Pictures were taken every 5 seconds for more than 15 minutes. Polarization of syndecan-1 to the neck of the uropod (trailing edge) of moving cells was confirmed (not shown).
Motility of myeloma cells correlates with the polarized phenotype
Migration of cells through a Transwell membrane was examined to see whether polarized morphology correlated with cell motility. There was a strong positive correlation between number of polarized cells in the cell lines and migration of the cells through the membrane (r = 0.89, P = .018) (Figure6 and Table 1). In various experiments with the CAG cell line, between 6% and 23% of the cells migrated to the lower chamber in 24 hours and up to 39.5% in 48 hours (not shown), which was several hundred-fold more than in U-266 and ARK, two cell lines with few polarized cells. Mononuclear cells from peripheral blood of a patient with plasma cell leukemia were also examined in this assay. More than 10% of the cells from this patient crossed the membrane. Seventy-three percent of the cells that were recovered in the lower compartment stained positive for syndecan-1, showing that they were plasma cells. Of the syndecan-1–positive cells, 79% had uropods, as opposed to only 46% in the original sample, indicating that uropods are indeed important for the ability to migrate.
Correlation between formation of uropods and migration of myeloma cells.
Myeloma cells were seeded in the upper chambers of Transwells (5 × 105 cells per well). After 24 hours, the cells that had migrated through 5-μm pores to the lower chambers were counted. The number above each bar shows the percentage of cells with uropods in that cell line.
Correlation between formation of uropods and migration of myeloma cells.
Myeloma cells were seeded in the upper chambers of Transwells (5 × 105 cells per well). After 24 hours, the cells that had migrated through 5-μm pores to the lower chambers were counted. The number above each bar shows the percentage of cells with uropods in that cell line.
To show that migration in this assay is an active process and not the result of cells passively diffusing through the membrane, migration of CAG cells was examined at both 4°C and 37°C. Under cold conditions, virtually no cells migrated into the lower chamber (not shown).
Adhesion between myeloma cells is mediated by uropod-to-uropod contact
In previous studies, we demonstrated that syndecan-1 mediates adhesion between myeloma cells and that syndecan-1 was concentrated at sites of cell-cell contact.3 Consistent with this, we observed that in myeloma cell lines in which uropods are most numerous (CAG cells and ARP-1), cell-cell attachment occurred preferentially at the uropods. This was true both in aggregates of 2 or a few cells (Figure 7) and in larger clusters of cells (not shown). In the latter situation, the uropods tended to be buried within the cell aggregates and the opposite poles pointing outward.
Contact between uropods of adjacent cells initiates myeloma cell-cell adhesion.
DIC image of live CAG cells. Homotypic aggregation occurs mainly at the uropod pole of the cells.
Contact between uropods of adjacent cells initiates myeloma cell-cell adhesion.
DIC image of live CAG cells. Homotypic aggregation occurs mainly at the uropod pole of the cells.
Myeloma cells may interact with bone-forming osteoblasts in the BM of patients with MM. When myeloma cell lines were seeded on top of confluent layers of HOS osteosarcoma cells, which are closely related to osteoblasts, a major proportion of the myeloma cells attached to the osteosarcoma cells. This happened in all cell lines examined, irrespective of whether the cells had uropods or not. However, when present, the uropod seemed to be the preferred or strongest point of contact. This was most conspicuous for ARP-1 cells, in which a major fraction of the cells had contact with the osteosarcoma cells only through the uropods (Figure 8).
Uropods act as attachment sites in contacts between myeloma cells and other cell types.
ARP-1 cells were seeded on a confluent layer of cells from the human osteosarcoma cell line HOS. After attachment of the myeloma cells, the coculture was stained with FITC–anti-syndecan-1 and studied with a confocal laser microscope. A stack of 60 pictures in the x-y plane was taken. The distance between adjacent pictures was 0.5 μm. Upper 3 pictures show 2 myeloma cells in the x-y plane with the picture number from the top of the stack indicated. The picture in level 50 also shows some staining of the adherently growing osteosarcoma cells. Lower panel is a z-section of the myeloma cells, showing uropods attaching to the osteoblast-like cells, which are faintly visible in the lower quarter of the picture.
Uropods act as attachment sites in contacts between myeloma cells and other cell types.
ARP-1 cells were seeded on a confluent layer of cells from the human osteosarcoma cell line HOS. After attachment of the myeloma cells, the coculture was stained with FITC–anti-syndecan-1 and studied with a confocal laser microscope. A stack of 60 pictures in the x-y plane was taken. The distance between adjacent pictures was 0.5 μm. Upper 3 pictures show 2 myeloma cells in the x-y plane with the picture number from the top of the stack indicated. The picture in level 50 also shows some staining of the adherently growing osteosarcoma cells. Lower panel is a z-section of the myeloma cells, showing uropods attaching to the osteoblast-like cells, which are faintly visible in the lower quarter of the picture.
Sequestering of heparin-binding molecules to the uropod
Because of the high concentration of syndecan-1 heparan sulfate in the uropods of polarized myeloma cells, we examined whether soluble heparin-binding molecules like HGF and OPG,22 23 would bind preferentially to this area of the cells. Cells were incubated with HGF or OPG, fixed, then washed and stained with anti-HGF or anti-OPG. Both molecules were concentrated in the uropods of polarized cells (Figure 9), whereas they were evenly distributed in cells without uropods (Figure 9B). Incubation of cells with HGF in the presence of heparin abolished HGF binding to the cell surface (Figure 9F), and a deletion variant of OPG lacking the heparin-binding domain did not bind to cells (not shown), indicating that both molecules are binding to the cells through interactions with cell surface heparan sulfate.
The heparin-binding proteins HGF and OPG bind specifically to the uropod of polarized myeloma cells.
CAG (A-F and I-J) and ARP-1 cells (G-H) were incubated with 4 μg/mL of HGF alone (A-E and G-H), with HGF and 40 μg/mL heparin (F) or with 10 μg/mL OPG (I-J) at 37°C, fixed, and stained with a mab against HGF (A-H) or OPG (I-J) as described in “Patients, materials, and methods.” (A-B), (C-D), and (I-J) are corresponding visual fields. Strong uropod restriction of HGF and OPG binding is seen. Heparin prevented binding of HGF to the uropod (F).
The heparin-binding proteins HGF and OPG bind specifically to the uropod of polarized myeloma cells.
CAG (A-F and I-J) and ARP-1 cells (G-H) were incubated with 4 μg/mL of HGF alone (A-E and G-H), with HGF and 40 μg/mL heparin (F) or with 10 μg/mL OPG (I-J) at 37°C, fixed, and stained with a mab against HGF (A-H) or OPG (I-J) as described in “Patients, materials, and methods.” (A-B), (C-D), and (I-J) are corresponding visual fields. Strong uropod restriction of HGF and OPG binding is seen. Heparin prevented binding of HGF to the uropod (F).
Preferential binding of HGF and OPG to uropods also indicates that most, if not all, heparan sulfate-containing molecules in myeloma cells are localized to the uropod in polarized cells. This was confirmed by the staining of ARP-1 cells with the antibody 10E4,24which recognizes heparan sulfate. Staining with 10E4 was, like the HGF-staining, tightly localized to the uropod (not shown).
Discussion
In this study, we show that myeloma cells can have a distinct polarized morphology with syndecan-1 specifically targeted to the uropod of these cells. The polarized myeloma cells exhibit high migratory potential, compared with nonpolarized cells, and are similar in morphology to that previously described for actively migrating lymphocytes and neutrophils.12,18,25 26 Moreover, consistent with the known function of syndecan-1 in mediating cell adhesion and growth factor binding, we show that the uropod of myeloma cells is the preferred site for myeloma cell-cell adhesion, and for attachment of heparin-binding proteins like HGF and OPG.
Syndecan-1 is an important regulator of myeloma cell behavior.27 It mediates myeloma cell aggregation, promotes cell binding to type I collagen, and inhibits invasion of myeloma cells into collagen gels.1-3 Syndecan-1 is shed from myeloma cells and soluble syndecan-1 can induce apoptosis of myeloma cell lines.17 Together, these data suggest that syndecan-1 acts to suppress myeloma cell growth and metastasis. However, a high level of syndecan-1 in the serum of patients with MM at diagnosis is a strong negative prognostic factor,28 raising the possibility that shed syndecan-1 could have adverse effects in vivo.
The finding that the uropod is the part of the cell predominantly involved in cell-cell adhesion is consistent with the distribution of syndecan-1 to this part of the cell. We have previously shown that syndecan-1, through its heparan sulfate chains, binds to an unidentified counter receptor on neighboring myeloma cells.3 The observation that uropod-uropod interaction is the rule in homotypic adhesion favors the hypothesis that this receptor is also localized in the uropod. ICAM-1, another adhesion molecule involved in homotypic adhesion of myeloma cells,29 also localizes to the uropod, further underscoring the importance of the uropod in cell adhesion. Our findings are also consistent with the reported localization of several adhesion molecules in the uropod of a moving immune cell.8
Our discovery that syndecan-1 concentrates HGF within the uropod supports the previous data suggesting that uropods participate in cell-cell communication.7 12 One of the ways heparan sulfate can influence cell signaling is by presenting heparin-binding cytokines to their high-affinity receptors, located either on the cell itself or on adjacent cells. By concentrating the major fraction of heparan sulfate to a small part of the cell surface, a much higher concentration of growth factor is achieved in this particular region. The higher concentration likely favors cross-linking of cytokine receptors, which is typically the signal-inducing event. A possible advantage of this is easily conceived in the case of cytokine presentation to adjacent cells. Concentrating heparin-binding cytokines in the membrane area in direct contact with the target cell will likely make most of the cytokine available to this cell, thus giving a much higher local concentration of the cytokine than what is present in the intercellular fluid.
The observation that myeloma cells are able to concentrate HGF in their uropods is of particular interest. Most myeloma cells produce HGF and increased serum HGF is an adverse prognostic factor in the disease.30,31 We have also shown that HGF induces interkeukin 11 (IL-11) production from osteoblasts, a cytokine that stimulates bone resorption.32 This effect of HGF was much more pronounced when myeloma cells were present. Myeloma cells incubated with HGF, thoroughly washed and cocultivated with osteoblast-like cells presented HGF to the latter cells. This HGF presentation was abolished by washing the myeloma cells with heparin after HGF incubation, showing that the effect was heparan sulfate-dependent.32 As shown in this paper, uropod-containing myeloma cells tend to attach to osteoblast-like cells via their uropods (Figure 8), suggesting that the uropod is the area involved in presentation.
Binding of OPG to syndecan-1 in myeloma cells is also likely to have biologic consequences. OPG is a decoy receptor for the principal osteoclast-activating molecule TRANCE33 and is a crucial molecule for prevention of excessive bone resorption.34 If syndecan-1 on myeloma cells sequesters OPG and prevents it from interacting with TRANCE, it could contribute to the bone destruction seen in MM.
In a series of experiments designed to see whether heparan sulfate is important for heterotypic adherence of myeloma cells to normal long-term culture bone marrow stromal cells, heparin was only slightly, and not consistently, able to reduce attachment of the myeloma cells (unpublished data), suggesting uropod heparan sulfate does not likely play a major role in binding myeloma cells to stromal cells.
Polarized myeloma cells, as described in this study, resemble “hand mirror cells,” a morphologic cell variant sometimes found in acute myeloblastic and lymphoblastic leukemias.35 Myeloma cells growing on fibronectin, an extracellular matrix component, altered their morphology, but the two opposite cell poles could still be identified. Interestingly, syndecan-1 and ICAM-1 retained their focal localization, although now in a perinuclear region at the neck of one of the two cell poles (Figure 5). However, in this situation a role of ICAM-1 and syndecan-1 in permanent attachment to the substrate was unlikely as this cell region usually pointed away from the fibronectin-coated surface. This is understandable because a cell in motion, at least intermittently, will have to keep adhesion molecules detached from fixed molecules in the extracellular matrix. The observation of uropods pointing toward the outer environment is in keeping with an earlier report, in which T lymphoblasts immobilized to a surface coated with ICAM-1 were shown to project their uropods away from the surface and contact other nonadherent T cells.12This way they were able to activate bystander cells and induce them to form uropods.
It was also apparent that uropods on cells in the process of adhering to fibronectin lost their attachment to other cells. This indicates that polarized cells, which have a migratory potential, in the absence of stimuli from a guiding substrate or from chemokines, can use their uropods in attachment to other cells but that this attachment is broken once a signal for migration is received.
Identification of a migratory cell pool in a disease in which the majority of the cells appear to be nonmotile is obviously of interest. Masellis-Smith and colleagues36 found that extramedullary myeloma cells from pleural effusion or peripheral blood of terminal patients tended to be motile and have “deformed plasma membrane,” whereas BM myeloma cells were immobile. It is not surprising that cells that have managed to move out of the marrow are motile. We confirmed this with cells from the patient with plasma cell leukemia in this study. It is more difficult to understand that motile myeloma cells should be absent in the BM of the patients. Considering the widespread nature of the disease, it seems likely that trafficking of myeloma cells occurs within the marrow. Consistent with this assumption, we found a few polarized myeloma cells in each of the 3 BM samples from which we cultured cells in vitro. In one patient, this cell fraction amounted to several percentages of the total cell count and the malignant cells showed localization of syndecan-1 to the uropod. Likewise, a BM sample from the patient with plasma cell leukemia contained almost the same fraction of polarized malignant cells as a peripheral blood sample. The fractions of polarized cells in these patients were much higher than in the bone marrow plasma cell populations from 7 healthy donors, showing that the motile phenotype of malignant plasma cells does not reflect normal plasma cell morphology but is related to malignant transformation.
Our observations support the conclusions in a study of long-term BM cultures from myeloma patients and healthy donors, in which a proportion of normal plasma cells and myeloma cells were found to have motility-associated morphologic features.37 In this study, such cells were also found in the majority of BM smears from patients with MM.
The correlation between the polarized phenotype and the capacity of myeloma cells to migrate (Figure 6) is of important physiologic significance. As we demonstrated in Figure 1, syndecan-1 and other adhesion molecules are tightly localized to uropods and likely anchor cells as the lamellipodial pole stretches forward to accomplish movement. Following this, there must then be a mechanism to release the tightly adherent uropod to allow the trailing edge of the cell to move forward. This scenario provides an explanation of how cells bearing adhesive molecules such as syndecan-1 can still be invasive under certain conditions. Once cells enter connective tissue and lose their polarity, the adhesion molecules redistribute over the entire cell surface, thereby rendering the cell immobile.
In conclusion, we have identified a morphologically distinct subpopulation of myeloma cells having a polarized phenotype. Syndecan-1 is targeted specifically to the uropod of those polarized cells in which it participates in mediating cell-cell adhesion and protein binding. Although the molecular mechanisms that direct targeting of syndecan-1 to uropod membranes are unknown, they likely include interactions between the syndecan-1 cytoplasmic domain and molecules that interact with the cytoskeleton. Further study is warranted to determine what regulates polarization of myeloma cells and subsequent targeting of syndecan-1 and other adhesion molecules to the uropod surface, and how these activities regulate tumor cell behavior.
Acknowledgments
We thank Dr Richard Kurten for help with the digital micrographs and with time lapse studies, Allison Theus for technical assistance, and Dr J. Kevin Langford, Dr Carla Pumphrey, Marie Lacy, and Jeff Woodliff for discussions and for comments to the manuscript.
Supported by The Norwegian Cancer Society, Dr A. Malthe's legat, Rakel and Otto Kr. Bruun's legat, and CA55819 and CA68494 from the National Cancer Institute, National Institutes of Health.
The publication costs of this article were defrayed in part by page charge payment. Therefore, and solely to indicate this fact, this article is hereby marked “advertisement” in accordance with 18 U.S.C. section 1734.
References
Author notes
Magne Børset, Institute of Cancer Research and Molecular Biology, Norwegian University of Science and Technology, Medical Technical Research Center, N-7489 Trondheim, Norway; e-mail:magne.borset@medisin.ntnu.no.